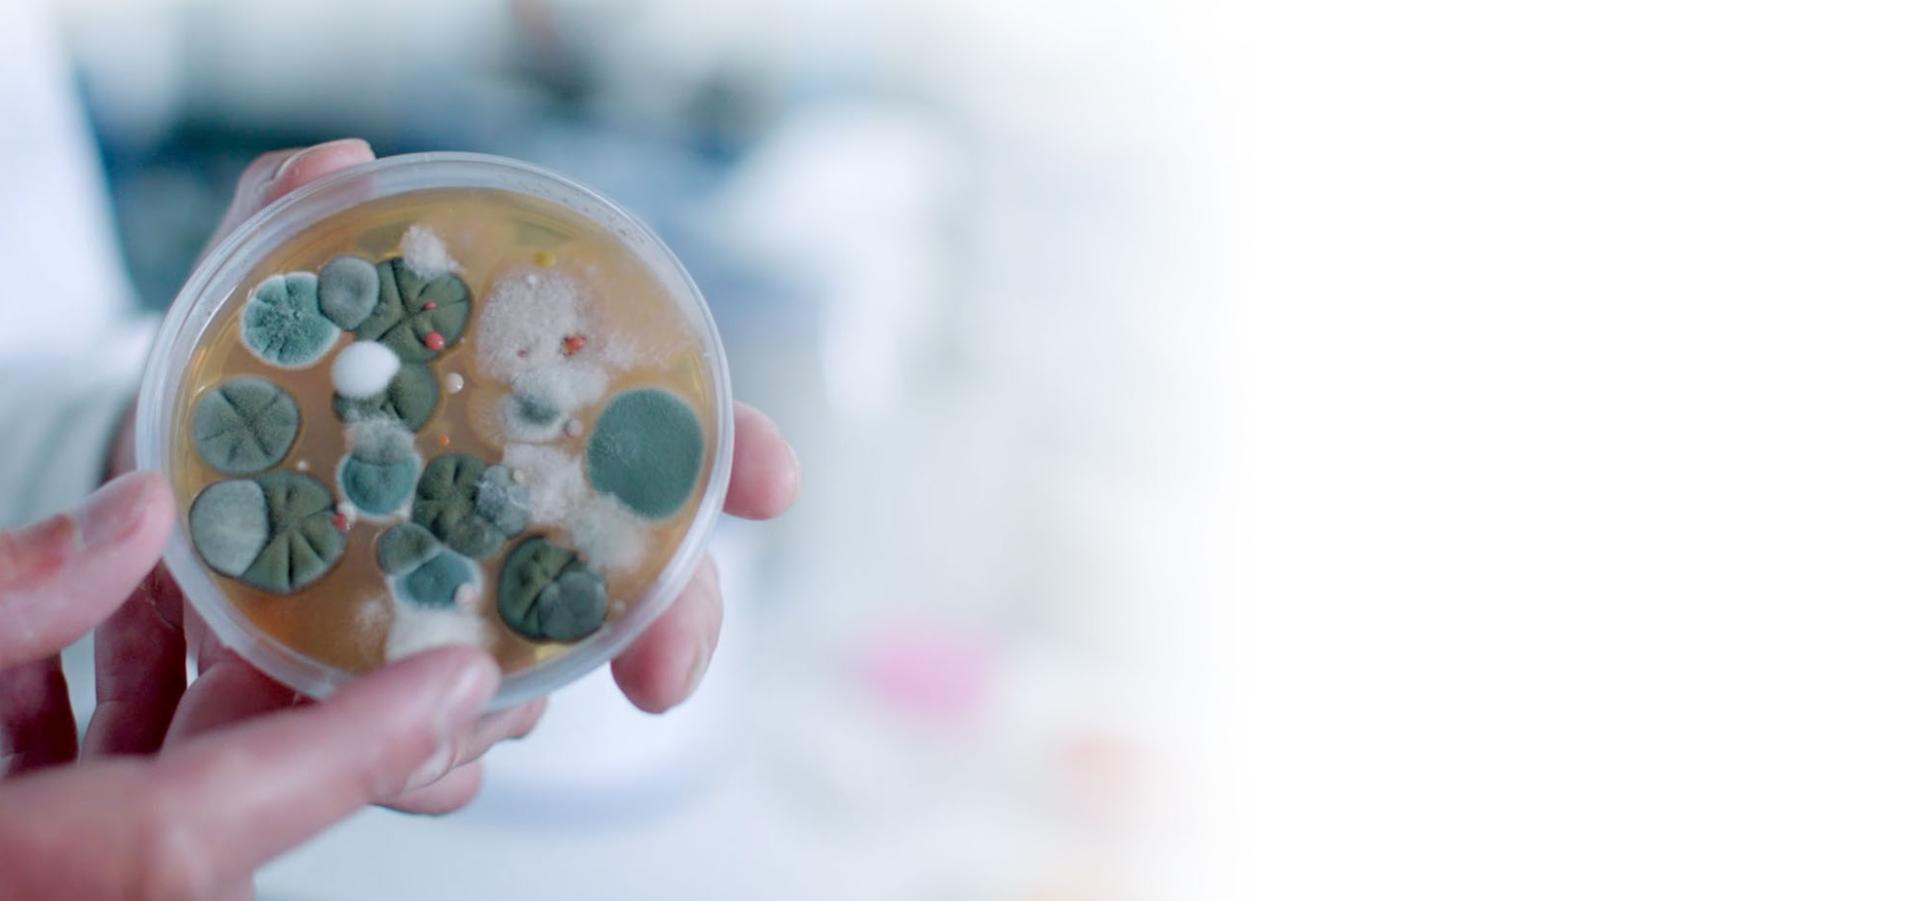
Luăm foarte în serios importanța curățeniei

Alege tehnologia Dyson pentru o casă mai curată și un mediu mai sănătos.
Vedeți cum cele mai noi modele de aspiratoare și purificatoare au fost proiectate pentru a asigura un mediu mai curat și mai sănătos.

Luăm foarte în serios importanța curățeniei
În laboratoarele noastre, experții în microbiologie studiază cum bacteriile, alergenii și alte particule microscopice se multiplică în casele noastre. Aceste studii ajută inginerii noștri să dezvolte produse care să capteze tot mai bine aceste micro-organisme din casele noastre.
Curățenie în profunzime. Captează 99,97% din particulele de dimensiuni de până la 0,3 microni inclusiv bacteriile și alergenii.
Aspiratoarele din gama Dyson V11 folosesc sistem de filtrare a aerului în 6 etape ce reține până la 99,97% din particulele de praf cu dimensiuni de până la 0,3 microni, mai mici în comparație cu bacteriile obișnuite. Sistemul de filtrare complet sigilat împiedică bacteriile să revină în aer odată ce acestea au fost aspirate.

Filtrele HEPA complet sigilate, captează 99,95% dintre particulele cu dimensiuni de până la 0,1 microni.
Purificatorul nostru de aer captează 99,95% din particulele ultrafine din aer2, în timp filtrul din cărbune activ elimină gazele potențial dăunătoare. Aerul purificat este apoi distribuit în întreaga cameră3 cu tehnologia Air Multiplier™.

Înlătură particulele pe care nu le putem vedea
Filtrele noastre ajută la crearea unui mediu mai sănătos prin captarea particulelor potențial dăunătoare. Filtrul HEPA 360° H13 captează particule PM0.1, inclusiv virusurile *. Filtrarea în șase etape din sistemul de sigilare al aspiratorului Dyson V11 ™ este proiectată pentru a captura praful și particulele fine de până la 0,3 microni - mai mici decât bacteriile obișnuite.
-
Bacterii și spori de mucegai
PM5.0
-
Emisii de gaze
PM2.5
-
Particule ultrafine și virusuri
PM0.1
-
Formaldehidă
-
Ozon
-
Benzen
-
Dioxid de Azot
-
Polen și alergeni
PM10